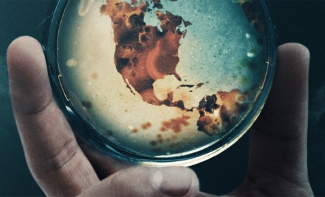

Mergi la pagina de început "Ion Anton" 
Poeta si scriitoarea Elena Calugaru Baciu1. Elena Călugăru Baciu, Vizita în California2. Aripa Frîntă, de Elena Călugăru Baciu3. Despre "Romanul Planetar" al lui Lucian Hetco4. Imn, de Elena Calugaru Baciu5. Treceri/Furișări de toamnă - Să nu-ți fie teamă!, de Elena Calugaru-Baciu6. Ramură de portocal7. O nouă crizantemă pe pământ8. Stejerel Colb de memorii9. Mama ei de balta10. Întâlniri în lumea nevăzută11. Uneori prietenie... alteori...12. Doar cateva minute...13. Elena Baciu Calugaru: „The memory of the living“14. Scriitoarea și poeta Elena Călugăru-Baciu - Opere Complete15. Fetița și Moș Nicolae [moment epic]16. Nevăzutul ucigaș17. Dialog cu un dinozaur pitic18. Despre Pandemia cu Coronavirus19. A fost Covid...a trecut!20. Litere...!21.Un porumbel1. Vizita în CaliforniaIar despre proza sa, Prof.dr.Th. Damian de la New York, scrie:"Sunt tentat de doua lucruri: sa incep o discutie teologica pe temele principale ale cartii, sau sa dau cat mai multe citate din ea pentru a fi sigur ca cei ce nu au sansa sa o cumpere, cel putin sa aiba o mica posibilitate de a-si face o idee despre ea. Nu voi face nici una nici alta. Voi lasa duhul cartii sa-si croiasca destinul in cultura romana."Aprecierile de mai sus sunt extrase din DICTIONARUL: "Personalitati romane si faptele lor" - editia 2003, care dictionar cuprinde si personalitatea Elenei Calugaru Baciu.Ocazii de a o intalni au fost mai multe, cand autoarea a făcut cinci lansari de carte, patru de proza scurta, si un volum bilingv de poezie (romana-engleza) toate oferindu-va si posibilitatea de a va imbogati colectia de carte, cumparandu-le in momentele de prezentare.Titlurile celor cinci lansari de carte sunt:-Gradinile lui Sebastian- proze scurte-Din nou Cain- roman-Jocul tipatului- proze scurte-Ambarcatiunea Arca- roman-Glosse-versuri bilingveIntalnirile cu cititorii au avut loc în 5 locații diferite în Sudul Californiei, astfel:
Înaintea sosirii sale în America, ELENA CALUGARU BACIU a facut o avanpremiera prin paginile Revistei Clipa cu doua articole pline de temperament: "Intalnire spirituala, este vorba de o intalnire la CHISINAU cu Acad. poet Grigore Vieru, cu Acad. Mihai Cimpoi si alte multe personalitati culturale, iar cu ocazia aniversarii zilei de nastere a Marelui EMINESCU, a scris un interesant articol filosofic- "Trairi catilinare".Și alte informatii de detaliu au fost publicate in REVISTA CLIPA.A consemnat Ion Anton |
|---|